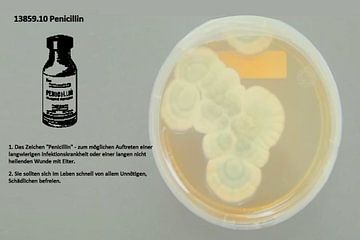

-
Doigts bandés 18481.10
108.- CHF97.- CHF ArtFrame™, 75x50 cm | Choisissez vous-même la dimension et le matériau
-
Pénicilline 13859.10
108.- CHF97.- CHF ArtFrame™, 75x50 cm | Choisissez vous-même la dimension et le matériau
-
Fracture 18530.10
108.- CHF97.- CHF ArtFrame™, 75x50 cm | Choisissez vous-même la dimension et le matériau
-
Écailles de tête 17104.10
108.- CHF97.- CHF ArtFrame™, 75x50 cm | Choisissez vous-même la dimension et le matériau
-
Foie 11955.10
108.- CHF97.- CHF ArtFrame™, 75x50 cm | Choisissez vous-même la dimension et le matériau
-
Pilules 18557.10
108.- CHF97.- CHF ArtFrame™, 75x50 cm | Choisissez vous-même la dimension et le matériau
-
Pilule 11958.10
108.- CHF97.- CHF ArtFrame™, 75x50 cm | Choisissez vous-même la dimension et le matériau
-
Pincette 11959.10
108.- CHF97.- CHF ArtFrame™, 75x50 cm | Choisissez vous-même la dimension et le matériau
-
Lépreux 14189.10
108.- CHF97.- CHF ArtFrame™, 75x50 cm | Choisissez vous-même la dimension et le matériau
-
Pommade 13674.10
131.- CHF118.- CHF ArtFrame™, 80x60 cm | Choisissez vous-même la dimension et le matériau
-
Mandragore 18249.10
131.- CHF118.- CHF ArtFrame™, 80x60 cm | Choisissez vous-même la dimension et le matériau
-
Permanganate de potassium 18255.10
131.- CHF118.- CHF ArtFrame™, 80x60 cm | Choisissez vous-même la dimension et le matériau
-
Marijuana 16997.10
131.- CHF118.- CHF ArtFrame™, 80x60 cm | Choisissez vous-même la dimension et le matériau
-
Masque cosmétique 18259.10
108.- CHF97.- CHF ArtFrame™, 75x50 cm | Choisissez vous-même la dimension et le matériau
-
Massage 16956.10
108.- CHF97.- CHF ArtFrame™, 75x50 cm | Choisissez vous-même la dimension et le matériau
Lire tous les évaluations Vladimir Zykunov
 Pays-Bas
Pays-Bas Commandé en juillet 2024
Commandé en juillet 2024
 Allemagne
Allemagne Commandé en janvier 2023
Commandé en janvier 2023
 Allemagne
Allemagne Commandé en mai 2020
Commandé en mai 2020
 Allemagne
Allemagne Commandé en janvier 2025
Commandé en janvier 2025
 Pays-Bas
Pays-Bas Commandé en novembre 2019
Commandé en novembre 2019
 Allemagne
Allemagne Commandé en décembre 2021
Commandé en décembre 2021
 Pays-Bas
Pays-Bas Commandé en novembre 2020
Commandé en novembre 2020
 Pays-Bas
Pays-Bas Commandé en avril 2019
Commandé en avril 2019
 Pays-Bas
Pays-Bas Commandé en septembre 2023
Commandé en septembre 2023
 Allemagne
Allemagne Commandé en août 2022
Commandé en août 2022
 Pays-Bas
Pays-Bas Commandé en juillet 2025
Commandé en juillet 2025
 Allemagne
Allemagne Commandé en mars 2025
Commandé en mars 2025